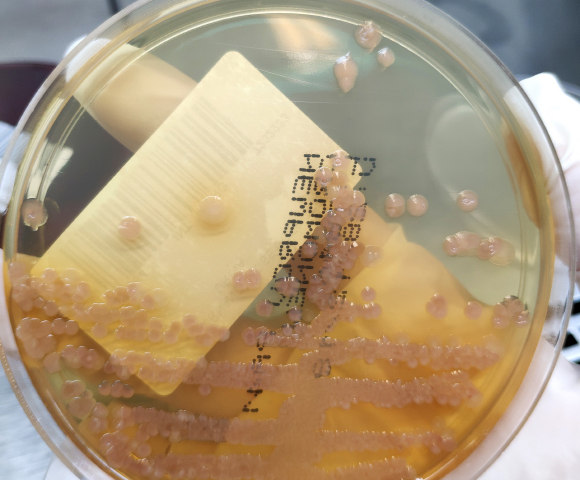
תרבית של חיידקי מורגנלה מורגני | Shutterstock, Frawash

סרטן המעי הגס הוא הסרטן השני בשכיחותו בישראל, לאחר סרטן השד. זוהי מחלה המאגדת בתוכה כמה סוגי גידולים המתפתחים בחלק הסופי של מערכת העיכול. לפעמים יש למחלה מרכיב תורשתי, ובדרך כלל מעורבים בה גורמים סביבתיים כגון עישון, אכילת בשר אדום או מחלות מעיים דלקתיות. איך גורמות מחלות דלקתיות לסרטן? יש יותר מדרך אחת, ובמחקר חדש, חוקרים מארצות הברית מצאו קשר נוסף בין השניים, בדמות מולקולות רעילות שמפרישים חיידקי מעיים מסוימים.
בעבר כבר התגלה כי מינים מסוימים של חיידקי מעיים מפרישים חומרים רעילים שגורמים נזק לחומר הגנטי (ה-DNA) של התאים בדפנות המעיים. שינויים כאלה שנגרמים ל-DNA נקראים מוטציות, וחלקם עלולים לעודד את התא הפגוע להתחלק באופן לא מבוקר – כלומר להפוך לתא סרטני. אך עד כה נמצאו רק דוגמאות בודדות של חיידקים כאלה, ולא תמיד היה ברור אם אכן יש קשר ישיר בין החומרים שהחיידקים הללו מפרישים להתפתחות הסרטן, ומהם המנגנונים האחראים לקשר הזה במקרה שהוא קיים.
קבוצת המחקר של הביולוג נואה פאלם (Palm) מאוניברסיטת ייל פיתחה שיטה חדשה על מנת לחקור בצורה שיטתית ונרחבת אם חיידקי מעיים עלולים לגרום נזק ל-DNA, איך נזק כזה יכול להתרחש ואילו חיידקים מעורבים בכך. השיטה ותוצאות המחקר פורסמו בכתב העת Science.

סרטן המעי הגס הוא הסרטן השני בשכיחותו בישראל, לאחר סרטן השד. צילום רנטגן של מטופל עם סרטן המעי הגס | Shutterstock, Suttha Burawonk
מדלקת לסרטן
החוקרים בודדו 122 זנים של חיידקים ממעיהם של חולים במחלות מעיים דלקתיות, כגון מחלת קרוהן. הם בחרו להתמקד בחולים האלה עקב הסיכון הגבוה שלהם לחלות בסרטן המעי הגס. החוקרים גידלו את החיידקים בתרבית שכללה גם DNA אנושי. כעבור יומיים הוציאו את מולקולות ה-DNA מהתרבית ובדקו בשיטות ביוכימיות אם נגרם לו נזק. נמצא שרוב החיידקים גרמו נזק כלשהו ל-DNA.
אחרי סדרה נוספת של ניסויים זיהו החוקרים 18 זני חיידקים שהנזק שגרמו ל-DNA היה גדול במיוחד. כעת, במטרה לבדוק אם החיידקים הללו מפרישים חומרים רעילים למצע הגידול, אספו החוקרים את מצע הגידול אחרי שהניחו לחיידקים להתפתח עליו במשך יומיים והוסיפו אותו לתרבית של תאי אדם. מצע הגידול של שבעה זני חיידקים לא גרם כל נזק לתאים, שני זני חיידקים אחרים הפרישו חומרים רעילים שהרגו את התאים, ואילו מצע הגידול של תשעה זנים גרם נזק ל-DNA של תאי האדם, אך לא קטל אותם.
מבין תשעת הזנים הללו, שניים היו שייכים למין מורגנלה מורגני (Morganella morganii). מכיוון שחיידקי מורגנלה נמצאו בשפע במעיהם של חולי מחלת קרוהן וגם אצל חולים בסרטן המעי הגס, התמקדו החוקרים בחיידקים האלה ובחומרים שהם מפרישים. בחינה כימית מדוקדקת זיהתה בין החומרים שחיידקי המורגנלה הפרישו משפחה של מולקולות בשם אינדולאימין (Indolimine), שגרמו נזק ישיר ל-DNA בתמיסה וגם ל-DNA שנמצא בתוך תאי אדם שגדלו בתרבית. מדובר בממצא חדשני, שכן עד כה לא תוארו חיידקים המפרישים את החומרים האלה.
מצע הגידול של חיידקי מורגנלה גרם נזק ל-DNA של תאי האדם. תרבית של חיידקי מורגנלה מורגני | Shutterstock, Frawash
בהמשך זיהו החוקרים את החלבון המעורב ביצירת האינדולאימין אצל החיידקים, ויצרו זן מהונדס של מורגנלה שאינו מסוגל לייצר אינדולאימין. הם שתלו במעיים של עכברי מעבדה את החיידקים המהונדסים, ונתנו לעכברים חומר מסרטן. כביקורת, שתלו אצל קבוצה נוספת של עכברים את החיידקים הרגילים, ונתנו להם את אותו חומר. כעבור חודשיים התברר שהעכברים עם חיידקי המורגנלה המהונדסים פיתחו מחצית מכמות הגידולים הסרטניים של העכברים עם חיידקי המורגנלה הרגילים. כמו כן, הגידולים שלהם היו קטנים יותר, ופחות אלימים.
זה המחקר הראשון שחקר באופן שיטתי את יכולותיהם של יותר ממאה זני חיידקי מעיים לגרום נזק ישיר ל-DNA, שעלול להתפתח לסרטן. באופן מפתיע – ומדאיג – רוב החיידקים שנבדקו גרמו נזק מסוים ל-DNA שעימו באו במגע ישיר, אולם רק מיעוט מביניהם פגעו פגיעה משמעותית בחומר הגנטי גם כאשר הוא היה בתוך תאי אדם חיים.
המחקר מצא סוג מולקולות חדש שחיידקים מפרישים, שגורמות נזק ישיר ל-DNA וכנראה מעודדות התפתחות גידולים סרטניים – אם כי עדיין יש לאשש את הממצאים הללו גם במחקרים על בני אדם. החוקרים אומנם התמקדו רק במין חיידקים אחד, אך ממצאיהם מחייבים להמשיך ולחקור את מעורבותם האפשרית של מיני חיידקים נוספים בהתפתחות סרטן המעי הגס. בסופו של דבר, מחקרים כאלה עשויים לסייע לפיתוח תרופות או טיפולים חדשים נגד החיידקים המזיקים או תוצריהם, וכך אולי למנוע התפתחות סרטן.